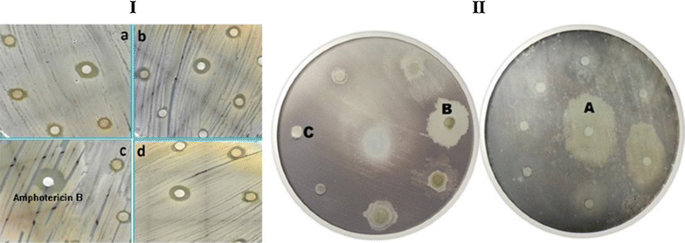
figure3

- Research
- Open access
- Published:
An assessment on the role of endophytic microbes in the therapeutic potential of Fagonia indica
Annals of Clinical Microbiology and Antimicrobials volume 16, Article number: 53 (2017)
Abstract
Background
Natural products of animals, plants and microbes are potential source of important chemical compounds, with diverse applications including therapeutics. Endophytic bacteria that are especially associated with medicinal plants presents a reservoir of therapeutic compounds. Fagonia indica has been recently investigated by numerous researchers because of its striking therapeutic potential especially in cancer. It is also reported that endophytes play a vital role in the biosynthesis of various metabolites; therefore we believe that endophytes associated with F. indica are of crucial importance in this regard. The present study aims successful isolation, molecular identification of endophytic bacteria and their screening for bioactive metabolites quantification and in vitro pharmacological activities.
Methods
16S rRNA gene sequencing was used for the identification of isolated endophytic bacteria. Methanolic extracts were evaluated for total phenolic contents (TPC), total flavonoids contents (TFC), DPPH free radical scavenging activity, reducing power and total anti-oxidant assays were performed. And also screened for antibacterial and antifungal activities by disc diffusion method and their MIC were calculated by broth dilution method using microplate reader. Further, standard protocols were followed for antileishmanial activity and protein kinase inhibition. Analysis and statistics were performed using SPSS, Table curve and Origin 8.5 for graphs.
Results
Bacterial strains belonging to various genera (Bacillus, Enterobacter, Pantoea, Erwinia and Stenotrophomonas) were isolated and identified. Total phenolic contents and total flavonoids contents varies among all the bacterial extracts respectively in which Bacillus subtilis showed high phenolic contents 243 µg/mg of gallic acid equivalents (GAE) and Stenotrophomonas maltophilia showed high flavonoids contents 15.9 µg/mg quercitin equivalents (QA), total antioxidant capacity (TAC) 37.6 µg/mg of extract, reducing power (RP) 206 µg/mg of extract and 2, 2-diphenyl-1-picrylhydrazyl (DPPH) free radical scavenging activity with 98.7 μg/mL IC50 value. Although all the extracts tested were active to inhibit growth of selected pathogenic microbes (bacteria and fungi), but significant antibacterial activity was observed against Klebsiella pneumonia and B. subtilis. An Enterobacter cloaca was active against Leishmania tropica with IC50 value of 1.4 µg/mg extracts. B. subtilis and Bacillus tequilensis correspondingly exhibit significant protein kinase inhibition of 47 ± 0.72 and 42 ± 1.21 mm bald zones, indicating anti-infective and antitumor potential.
Conclusions
Our findings revealed that crude extracts of selected endophytic bacteria from F. indica possess excellent biological activities indicating their potential as an important source of antibiotics (antifungal, antibacterial) compounds.
Background
Drug resistance has created new health challenges for humans. Over the years, emergence of new infectious diseases such as Ebola, Swine flu (H1N1), Dengue fever and severe acute respiratory syndrome (SARS), have been added to this challenges [1]. There is a general need for chemotherapeutic agents, antibiotics and pharmaceutical drugs with high effectiveness and low cytotoxicity. New medicinal agents are also needed for nematode infections such as malaria and for the treatment of parasitic protozoan diseases such as leishmaniasis and trypanosomiasis [2].
Natural resources are the potential source of novel bioactive molecules and can be used in the treatment of various infections. Such sources may include various forms of life like plants, marine macro-organisms (sponge, corals and algae) and endophytes (fungi, bacteria and actinomycetes) [3]. Plants which are used in traditional medicines are of significant importance and therefore considerable research has been carried out on medicinal plants for bioactive compounds however limited research has been performed on the associated microorganisms. Endophytes are chemical synthesizer inside plants. They play a role as a selection system for microbes to produce pharmacologically active substances with low toxicity toward mammalians [4]. Endophytes are sometimes responsible for the medicinal properties of their hosts. Many endophytes synthesize bioactive compounds that can be used by plants for defense against pathogens and some of these compounds may be valuable as pharmaceutical drugs [5].
Fagonia indica is a small spiny shrub that belongs to the family Zygophyllaceae present in warm and arid regions of the world, especially Asia and Africa [6]. Fagonia indica is of great ethno pharmacological importance with multiple therapeutic activities such as antimicrobial, antioxidant, antiseptic, anticancer, antidiabetic and anti-inflammatory [7]. The plant is also used for the treatment of fever, thirst, vomiting, asthma, urinary discharge, dysentery, liver and stomach trouble, toothache, typhoid and skin diseases [8].
This study was designed to investigate the role of endophytic bacteria in the medicinal properties of F. indica. Bacteria were isolated, identified and screened for the production of bioactive secondary metabolites. All the experiments were carried out in the Molecular Systematics and Applied Ethnobotany Lab, Department of Biotechnology, Quaid-i-Azam University, Islamabad.
Methods
Plants collection and identification
The plant samples were collected in sample bags from village Mullazai, Peshawar, Khyber PakhtunKhwa, Pakistan and brought to the laboratory at the same day for the isolation of endophytic bacteria. The plant material was taxonomically identified as F. indica at the Department of plant sciences, Quaid-i-Azam University Islamabad. To further confirm the taxonomic validity of the plant species, DNA barcoding was executed using cDNA markes such as matK, rbcL and trnH-psbA. Herbarium specimen (Voucher No. MOSEL-320) was deposited in the herbarium of Molecular Systematics and Applied Ethnobotany Lab at Department of Biotechnology; Quaid-i-Azam University, Islamabad.
Isolation of endophytic bacteria from stem of Fagonia indica
The stem of the plant was cut into pieces of about 0.5–1 cm in length and surface sterilized with 70% ethanol for 2 min followed by washing with Clorox (commercial bleach) for 5 min and finally rinsing at least three to five times with sterile distilled water. Stem pieces (5–6) were blotted on the blotting paper [9] and placed on selected Tryptic Soy Agar (TSA) media for the isolation of endophytic bacteria. The plates were incubated at 30 °C for 24 h to obtain colonies of bacteria.
Molecular identification of isolated endophytic bacteria
Bacterial genomic DNA was isolated using alkaline lysis method and 16S rRNA gene was amplified by performing colony PCR using universal bacterial primers 27F and 1492R, which produced a product of size 1465 base pairs [10]. Purification of PCR product was done by using pure LinkTM Quick PCR purification Kit (Invitrogen). Sanger sequencing method was used to commercially sequence the purified PCR samples with 27F primer from Macrogen (South Korea). Sequence results obtained were compared with nucleotide sequences available on NCBI database (www.ncbi.nlm.nih.gov/BLAST) and also confirmed from EZ-taxon (http://www.ezbiocloud.net/eztaxon). Sequences of endophytic bacteria were submitted to the GeneBank (NCBI) and Accession numbers were obtained.
Extraction of secondary metabolites
Selected bacterial strains were inoculated in Tryptic Soye Broth and incubated for 48 h in shaking incubator at 30 °C at 120 rpm. Bacteria were then transferred into 50 mL falcon tube and centrifuged at 10,000 rpm for 10 min. The supernatant was separated in the tube and the pellet was processed further. Pellet was dissolved in organic solvent (methanol) and incubated for 1 day. Next day sonication was performed to rupture the cells for 30 min after every five min. After sonication the tubes were centrifuged for 10 min at 10,000 rpm. The organic supernatant was separated in the falcon tube (A) and in the remaining pellet, again organic solvent methanol was added and centrifuged for 10 min at 10,000 rpm. Supernatant was separated in the falcon tube (B). The pellet was discarded and both the solvents (A) and (B) were mixed. The solvent was evaporated at room temperature to get crude extract of bioactive metabolites. The extract was dissolved in (dimethyl sulfoxide) DMSO [11].
Biological evaluation
Total flavonoid (TF) and total phenolic contents (TPC) determination
Total flavonoid contents (TFC)
Aluminum trichloride (AlCl3) colorimetric method was used for total flavonoids content determination as described by Quettire-Dele et al. [12] with slight modifications as per system suitability. An aliquote of 20 μl of the test sample (4 mg/mL) along with negative and positive controls i.e. DMSO and quercetin (1 mg/mL) respectively were taken in 96-well plate and incubated for 30 min at 37 °C. It was followed by the addition of 10 µl of aluminum chloride (10%), 10 µl potassium acetate (98.15 g/l) and final volume was raised up to 200 µl with distilled water. Absorbance was measured at 405 nm through micro plate reader (ELx800BioTek) and triplicate results were analyzed as µg QE/mg extracts.
Total phenolic contents (TPC)
Folin-Ciocalteu method as described by Jagadish et al. [13] with slight modifications was followed for TPC determination. Calculated volume of test sample 20 µl was taken form 4 mg/mL stock solutions and added to 96 well plates followed by addition of 90 µl of 10 times diluted Folin-Ciocalteu reagent incubated for 5 min. After incubation, 6% sodium chloride solution was added to each mixture and incubated for 90 min at room temperature. DMSO and Gallic acid (1 mg/mL) were taken as negative and positive controls, respectively. Absorbance was measured at 630 nm wave length of triplicate analysis and results were expressed in term of mean ± SD.
Determination of antioxidant potential of crude extracts
Radical scavenging activity-DPPH assay
The method described by Tai et al. [14] was used for the determination of free radicals scavenging activity with minor modification. The antioxidant potential of the crude extracts was gauged by monitoring its capacity to quench the stable 2, 2-diphenyl 1-picrylhydrazyl (DPPH) free radical. Activated crude extract samples of bacterial endophytes i.e. 100, 50, 25 and 12.5 µg/mL were taken in 96 well plates. DPPH was added to the entire row of well containing samples to obtain the final concentration of 200 µl. DMSO and ascorbic acid were taken as negative and positive controls, respectively. The absorbance was measured at 630 nm using microplate reader (ELx800 BioTek) after 1 h of incubation at room temperature. IC50 values expressed as µg AAE/mg of extracts. Percent radical scavenging was calculated by using formula:
Total antioxidant capacity estimation
Total antioxidant assay was performed to evaluate the total antioxidant capacity of extracts by phosphomolybdenum method [15]. The method depends on the reduction of Mo (VI) to Mo (V) by the consequent formation of a green colored phosphate/Mo (V) complex with a maximal absorption at 630 nm and through antioxidant mediators [16]. Reaction mixture contains 180 µl of phosphomolybdenum reagent (0.6 M H2 SO4, 28 mM NaH2PO4, 4 mM ammonium molydate) and 20 µl of test sample taken from stock solution (4 mg/mL) followed by incubated for 90 min at 95 °C in water bath. After incubation, samples had been cooled at room temperature and transferred to 96 well plates. DMSO and ascorbic acid were taken as negative and positive controls, respectively and absorbance was measure at 630 using microplate reader (ELx800 BioTek). Results were calculated as the number of µg equivalents of ascorbic acid per mg of extract (µg/mg). The experiment was performed in triplicate.
Total reducing power estimation
The method described by Oyaizu et al. [17] was followed for the estimation of total reducing power with minor modifications. A proper volume of test samples 40 µl from the stock solution (4 mg/mL) was taken in eppendrof tubes and incubated in water bath for 20 min at 50 °C, after the addition of reagents 0.2 M Phosphate buffer (6.6 pH) and 1% Potassium ferri cyanide [K3Fe (CN)6] (1 g 100 mL−1). After incubation 10% trichloroacetic acid was added to all tubes and centrifuged at 2500 rpm for 10 min. 166.66 µl supernatant from each centrifuge mixture was taken and transferred into 96 well microplate followed by the addition of 33.3 µl ferric chloride (0.1%) solution to each well and mixed properly. Absorbance was measured at 630 nm through micro plate reader (ELx800 BioTek). Results were calculated as µg AAE/mg extracts of triplicate analysis. DMSO and ascorbic acid were used as negative and positive controls, respectively.
Antimicrobial activity
Antifungal assay
Triplicate analysis by disc diffusion method was used to evaluate the antifungal potential of test extracts described by Lai et al. [18] with some modification. Crude extracts were screened against four fungal pathogenic strains: Mucor mycosis (FCBP (Fungal culture bank of Pakistan) -0041), Aspergillus flavus (FCBP-0064), Aspergillus fumigates (FCBP-1264) and Aspergillus niger (FCBP-0198). Dimethyl sulfoxide (DMSO) disc was used as negative control whereas amphotericin B was used as positive control. Plates were incubated at 37 °C for 24–48 h with periodic observations of inhibition zones. Extracts were screened to determine minimum inhibitory concentration (MIC) producing an inhibition zone ≥10 mm in diameter at lower concentrations ranging from 100 to 12.5 μg/disc by standard disc diffusion method.
Antibacterial assay
In vitro antibacterial potential of the test extracts was evaluated using 96 well microplates method as described previously by Gao et al. [19] with slight modifications. The extracts were tested against gram positive bacteria: Bacillus subtilis (ATCC-6633), Staphylococcus aureus (ATCC-6538), Micrococcus luteus (ATTC-10240) and gram negative bacteria: Escherichia coli (ATCC-15224), Salmonella typhi (ATCC-14028) Pseudomonas aeruginosa (ATCC-9721) and Klebsiella pneumonia (ATCC-4619). Bacterial strains were inoculated in 10 mL TSB and incubated for 24 h at 37 °C at 120 rpm in shaking incubator. For each bacterial strain, a standardized inoculum (1 × 108 CFU/mL) was prepared. The test samples were used in three fold dilutions i.e. 100, 33.3, 11.1 and 3.7 µg/mL. DMSO was used as negative control and cefixime monohydrate (antibiotic) as positive control, respectively. Reading was initially taken at zero hours and then again after 24 h incubation through microplate reader (ELx800BioTek) at 630 nm wave length [20]. The corresponding 50% inhibitory concentration (IC50) of each sample was calculated.
Antiprotozoal activity
Antileishmanial assay
The process described by Ma et al. [21] was used for in vitro antileishmanial activity with slight modifications against Leishmania tropica in their promastigote stage. The parasite was sub cultured in the RPMI 1640 medium supplemented, 292 µg/mL l-glutamine, 4.5 mg/mL glucose and 10% fetal bovine serum (FBS). Within these culture conditions, the stationary phase of parasite growth was obtained in 6 days. The culture was incubated at 25 °C and used within 2 weeks of cultivation. Antileishmanial activity of extracts in comparison to amphotericin B drug was evaluated against parasite using MTT 3-(4, 5-dimethylthiazol-2-yl-2, 5-diphenyltetrazolium bromide) based micro assay as a marker of cell viability. The bacterial extract samples were tested at lower concentration with three-fold serial dilutions and relative optical density (OD) was taken at 540 nm through micro plate reader (ELx800BioTek). IC50 values were obtained from the dose–response curves generated by plotting percent growth versus drug concentration. Percent viable cells were calculated by using the formula.
Protein kinase inhibition assay
The protein kinase inhibition assay was performed thrice with purified isolates of Streptomyces 85E strain by observing hyphae formation using ISP4 selective media [22]. The prepared media was subjected to autoclaving for 20 min at 121 °C and poured in the petri plates (autoclaved) under Laminar flow cabinet to avoid contamination. After solidification of the media, Streptomyces culture broth was spread on the surface of media with sterilized cotton swab. The test samples 20 mg/mL were tested on this media using the disc diffusion method. Plates were incubated at 37 °C for 24–48 h. The zone formation was measured through Vernier caliper. Surfactin (antibiotic) was used as positive control while DMSO as negative control, respectively. Two types of zones were observed clear and bald in which the bald zones showed protein kinase inhibition activity [23].
Statistical analysis
All experiments were conducted in a completely randomized design at least three times. Statistical analysis was carried out using SPSS 22.0 and Statistic 8.1. The relationship between different parameters was assessed using Pearson’s correlation coefficient (r). One-way ANOVA was used to check the significant mean difference with Tukey’s HSD for post hoc analysis. A P < 0.05 was used to define significant results. All the graphs were made using Origin 8.1 and Duncan’s multiple-range test was used to find differences among treatments (P < 0.05).
Results
Isolation and identification of endophytic bacteria
The isolated bacteria form F. indica [MOSEL (Molecular Systematic and Applied Ethno-botany Lab)-FLS1, MOSEL-FLS2, MOSEL-FLS3, MOSEL-FLS4, MOSEL-FLS5, MOSEL-FLS6, MOSEL-FLS7, MOSEL-FLS8] (5.78 × 101 CFU/mL) were identified based on 16S rRNA gene sequence analysis. The results revealed that all bacterial isolates from the stem of F. indica belongs to 5 different genera namely: Bacillus, Erwinia, Pantoea, Enterobacter and Stenotrophomonas. The nucleotide sequences obtained in this work were deposited in GenBank under accession numbers KT367786–KT367793 (Table 1).
Biological evaluation
Total flavonoid (TFC) and total phenolic contents (TPC) determination
Total flavonoid content (TFC)
The methanolic bacterial crude extracts show the presence of wide range of flavonoids contents [Figs. 1A, 2a (Standard curve)]. Among bacterial extracts S. maltophilia shows highest flavonoids contents of 15 µg/mg of extract followed by Enterobacter cloacae and B. subtilis with 11 µg/mg of extracts, Erwinia sp. and P. cypripedii shows 10 µg QE/mg of extract.
A TFC (total flavonoid content µg QE/mg), B TPC (total phenolic content µg GAE/mg), C TAC (total antioxidant capacity µg AAE/mg), D TRP (total reducing power µg AAE/mg) of bacterial crude extracts EH (Enterobacter hormaechei), SM (Stenotrophomonas maltophilia), BT (Bacillus tequilensis), ES (Erwinia sp.), PD (Pantoea dispersa), PC (Pantoea cypripedii), EC (Enterobacter cloacae) and BS (Bacillus subtilis). Lowercase letters compare the bacterial crude extract and control in the same concentration using one-way analysis of variance (ANOVA), followed by Tukey’s HSD (honestly significant difference). Same lowercase letters—no statistically significant difference (P > 0.05). Different lowercase letters—statistically significant difference (P < 0.05)
Standard curves labeled with letters from a to e. a Quercetin calibration curve (y = 0.0514x + 0.039, R2 = 0.9976) for total flavonoids contents (TFC) estimation. b Gallic acid calibration curve (y = 0.0475x + 0.0303, R2 = 0.9996) for total phenolic contents (TPC) determination. c Ascorbic acid calibration curve (y = 0.0447x + 0.1, R2 = 0.9866) for total reducing power (TRP) analysis. d Ascorbic acid calibration curve (y = 0.019x + 0.0657, R2 = 0.9971) for total antioxidants capacity determination. e Ascorbic acid calibration curve (y = 0.002x + 0.0997, R2 = 0.9778) for DPPH free radical scavenging activity analysis
Total phenolic contents (TPC)
Bacterial crude extract shows high range of total phenolic contents. The values varied from 13 to 243 µg gallic acid equivalents per mg of extract. In our study the highest content of Gallic acid equivalent phenols was observed in extract of B. subtilis with 243 µg GAE/mg of extract followed by S. maltophilia. Whereas, Erwinia sp., E. hormaechei and B. tequilensis extracts contained considerably least concentration of phenols [Figs. 1B, 2b (Standard curve)].
Determination of antioxidant potential of crude extracts
DPPH radical scavenging activity
The percent free radical scavenging activity (%RSA) of the bacterial crude extracts was evaluated by the discoloration of DPPH reagent. The reaction was visible as a color change from reduction of the purple colored DPPH to stable yellow-colored 2, 2-diphenyl-1-picrylhydrazyl molecule by hydrogen radical or accepting electron from donor antioxidant. Results were evaluated by calculating the half maximal (50%) inhibitory concentration. It was found that S. maltophilia possess highest free radical scavenging activity with 98.7 µg/mL inhibitory concentration (IC50 value), followed by P. dispersa and E. cloacae having 157.6 and 228.3 µg/mL IC50 values. Ascorbic acid was taken as standard and percent DPPH free radical scavenging activity of each endophytic bacterial extracts are shown in Table 2. [Fig. 2e (standard curve)].
Total antioxidant capacity
Estimating total antioxidant capacity. It was found that S. maltophilia show maximum antioxidant activity among all the bacterial extracts with 37 µg/mg value followed by E. cloacae, P. cypripedi and B. subtilis with 35, 34 and 31 µg/mg total antioxidant capacities [Figs. 1C, 2d (standard curve)].
Reducing power
Reducing ability was measured by change of Fe3+ to Fe2+ in reducing power assay. Extracts were checked for their antioxidant reducing power. S. maltophilia and P. dispersa results indicated their electron donor ability for stabilizing free radicals and greater reductive potential with highest reducing power i.e. 206 and 175 µg ascorbic acid equivalents per mg of extract. Activity of all bacterial extracts equivalent to ascorbic acid with respect to their absorbance values were shown in Figs. 1D and 2c (standard curve).
Antimicrobial assays
Antibacterial assay
In antibacterial assay, all bacterial extracts show inhibition against two strains of pathogenic bacteria B. subtilis and K. pneumonia. Against K. pneumonia, bacterial extracts showed IC50 values ranging from 1 to 20 μg/mL with variable inhibition from 55 to 82 at a concentration of (100 µg/mL). While in case of B. subtilis the extracts show variable IC50 ranging from 27 to 365 μg/mL with percent inhibition from 0 to 76. The inhibition value and effective IC50 value of different endophytic bacterial extracts against K. pneumonia and B. subtilis were shown in (Table 3).
Antifungal assay
Antifungal activity of bacterial crude extracts was determined against four strains of filamentous pathogenic fungi namely; Mucor mycosis, Aspergillus flavus, Aspergillus fumigatus and Aspergillus niger through disc diffusion method. All the bacterial genera showed inhibitory activity against all the selected pathogenic fungi. Almost all the bacterial extracts were active against A. niger but significant results observe are of Stenotrophomonas maltophilia with 16 mm inhibitory zone and 12.5 μg/mL MIC value (Table 4; Fig. 3). Although best results showed by B. tequilensis extracts against M. mycosis with maximum zone of 12 mm and 50 μg/mL MIC whereas all the extracts shows moderate antifungal activity against A. fumigatus with an average diameter of growth inhibition zone ranging from 7 to 10 mm. Moreover, no inhibitory zone was observed for DMSO which conform its inactivity against the selected fungal strains. Although standard drug amphotericin B Exhibited maximum, activity with 21.2 ± 0.985 mm zone.
Section labeled as “I” shows antifungal activity of bacterial crude extracts against pathogenic strains (a) Aspergillus niger, (b) Mucor mycosis, (c) Aspergillus fumigatus, (d) Aspergillus flavus. Section “II” indicates protein kinase inhibition activity of bacterial extracts using streptomyces strain as model organism (A represent bald zone, B clear zone and C no zone)
Antiprotozoal activity
Antileishmanial assay
Antileishmanial activity against promastigote was determined by MTT assay. Variation was observed between bacterial extracts (Table 5) activities against promastigote stage of L. tropica with IC50 values ranging from 1.4 to 6.6 μg/mL with different concentration. E. hormaechei has high inhibition with IC50 value of 1.4 followed by P. cypripedii and B. tequilensis with IC50 values of 1.5 and 1.6 µg respectively.
Protein kinase inhibition assay
In the current study, endophytic bacterial crude extracts were screened for the inhibition of protein kinases with Streptomyces sp. The growth inhibition of Streptomyces strain was used as parameter to check the cytotoxicity of endophytic crude extracts. Clear zone indicates no bacterial growth having cytotoxicity while a bald zone with doted bacterial growth indicates protein kinase inhibition. In bald zone, only the hyphae formation capability of Streptomyces was lost. In clear zones, complete cells were destroyed. Bacterial extracts of genus Bacillus show high inhibition value against Streptomyces growth such as B. subtilis and B. tequilensis with 47 ± 0.72 and 42 ± 1.21 mm zone of inhibition, respectively with bald zones formation which show protein kinase inhibition activities DMSO show no-toxic effect with no zone formation while positive control surfactin show the bald zone formation with 21 ± 1.02 mm (Table 6; Fig. 3).
Discussion
A large number of bioactive metabolites with pharmacological properties have been isolated from medicinal plant’s endophytes and structurally illustrated by employing various conventional as well as modern techniques. These metabolites have provided a base line for the researchers to do more work on development and formulation of bioactive compounds into useful therapies with tremendous applications in health care system and also in many other fields of human life.
Bacteria are common inhabitants of both internal and external tissues of most plants [12]. Medicinal plants usually harbor endophytes related with their secondary metabolites and medicinal activities [5]. The present study was conducted on endophytic bacteria, isolated from F. indica with great ethno-botanical significance. It is reported that medical uses of a plant with medicinal history relates more to its endophytic population than its own biochemistry [5]. Many biological assays were conducted to investigate whether bacteria associated with F. indica have potential medicinal properties. The isolated endophytic bacteria belong to diverse genera such as Bacillus, Enterobacter, Pantoea, Erwinia, Stenotrophomonas as confirmed with 16S rRNA gene sequence analysis.
It was observed from the results that all the selected bacterial extracts exhibit various anti-bacteria, anti-fungal and protein kinase inhibition activities. Antioxidants are the first line of defense against damage that may occur due to the generation of free radicals. Antioxidants deactivate or stabilize free radicals before they attack the cells [24].
The free radical DPPH scavenging activity model is a simple, rapid and classic method of assessing antioxidant activity [25]. Methanolic extracts of endophytic isolates were able to reduce the stable radical DPPH to a yellow-coloured diphenyl picryl hydrazine. Among others, the culture extracts of S. maltophilia and P. dispersa showed the highest % scavenging activities which is considerable as compared to control (i.e. Ascorbic acid equivalent). IC50 value is a widely used parameter for the measurement of free radical scavenging activity. Low IC50 indicates significant activities as compared to high IC50 value [26]. The current results are in agreement with the previous study reported by [27], about endophytic bacteria associated with ethno-medicinal plants.
Oxidation in biological system is natural phenomenon resulting in the generation of highly reactive peroxyl and hydroxyl radical which may cause inadequate damage to DNA, polyunsaturated fatty acid residues of cell membrane, phospholipids and proteins. It may also lead to pathological effects such as cancer and vascular diseases [28]. Among the extracts total antioxidant activity of S. maltophilia was the highest followed by E. cloacae strain.
Reducing ability of a compound depends on the free radical scavenging capacity and electron donation [29]. Endophytic bacteria isolated from Centella asiatica, Pantoea species such as Pantoea agglomerans showed greater reductive potentials reported by Rafat et al. [30]. All bacterial extracts were subjected for their reducing power but S. maltophilia and P. dispersa showed the highest values indicating their electron donating ability for stabilizing free radicals and showed the similar reductive potential as reported above.
High antioxidant potential is usually related with higher proportion of the phenolic content and in the present study a significant correlation was also found in case with S. maltophili. The current results are in agreement with the previous study reported by Swarnalatha et al. [31].
Flavonoids have an important role in stabilizing lipid oxidation which is associated with antioxidant activity [32]. In present study highest flavonoid content was displayed by S. maltophilia culture extract which correlates with its highest radical scavenging and greatest reductive potential as discussed earlier. Which are in agreement with the study reported by Jalgaonwala et al. [33] about endophytic bacteria associated with host plant Pongamia glabra.
All isolated of endopytes extracts from F. indica showed varying degree to inhibited test organism growth but significant results were observe against K. pneumonia by each extracts. Bacterial extracts of S. maltophilia, E. hormaechei, B. tequilensis and Erwinia sp. also showed significant antibacterial activity against B. subtilis, with variable inhibition and IC50 values. The crude extract of isolated B. subtilis strain showed no growth inhibition against the B. subtilis which show their similar metabolites productions and thus have no effect on test strain.
Moreover, extracts of all the endophytic bacteria inhibited the growth of nearly all the tested fungal pathogens. In current study the extracts producing a growth inhibitory zone ≥10 mm in agar disc diffusion assay were considered significant active. Significant result was observed by S. maltophilia against A. niger with 16 mm inhibitory zone and 12.5 μg/mL MIC value and B. tequilensis extracts against M. mycosis with maximum zone of 12 mm and 50 μg/mL MIC. Which is an agreement with the previous results reported by [34] Non-toxic effect of DMSO was confirmed through absence of growth inhibition zones while standard drug amphotericin B exhibited inhibitory zone of (21.2 ± 0.985).
Leishmaniasis, is a vector- borne disease caused by obligate intra-macrophage protozoa [35]. More investigations required to find anti-leishmanial effect by using Leishmania amastigote through different in vitro assays and then to investigate in vivo activity in laboratorial infected animals which would help in obtaining a novel drug that could potentially be cost-effective against the leishmania parasite and less toxic [36]. Most of the isolated endophytic bacterial crude extracts showed antileishmanial activities against leishmania tropica with IC50 values ranging from 1.4 to 6.6 μg/mL.
Protein phosphorylation at threonine/serine and tyrosine residues by protein kinases is one of the major regulatory mechanisms in biological processes including cell proliferation, cell differentiation metabolism and apoptosis. Deregulated phosphorylation at serine/threonine and tyrosine residues by protein kinases produced as a result of genetic alterations acquired early in tumorigenesis are often the cause of cancer. In this respect, inhibition of protein kinases has emerged as a promising target for cancer treatment [37]. Using streptomyces 85E as an assay strain for kinase inhibitors appears to identify a wide range of eukaryotic kinase modulators, presumably because the Streptomycete enzymes are evolutionary forerunners of their highly specific eukaryotic counterparts [38].
The growth inhibition of Streptomyces strain was used as parameter to check the protein kinase inhibition of the crude extracts. Bacterial extracts of genus Bacillus showed high inhibition zone against Streptomyces growth. B. subtilis and B. tequilensis showed bald zone formation (with 47 ± 0.72 and 42 ± 1.21 mm zone respectively), positive control Surfactin also exhibit bald zone which indicate protein kinase inhibition activities. Extracts were used in concentration of 100 µg/mL while positive control with 25 µg/mL. B. subtilis is the source of surfactin antibiotic production as isolated and reported by [39]. Protein kinase activity is critical for the aerial hyphae formation of Streptomyces and this prerequisite has been exploited in the present study to bioprospect the extracts for their kinase inhibitory activity so that their anticancer potential could be assessed.
Conclusions
From the preliminary study, it can be inferred that endophytes play a pivotal role in the medicinal activities of plants such as F. indica. We conclude excellent biological activities for the endophytic microorganisms associated with F. indica and postulate a viable role of the endophytic microbes in the medicinal potential of F. indica. We further recommend studies on the endophytic microbes associated with F. indica with state of the art spectroscopic and chromatographic techniques for the identification of targets and mechanism of their synthesis.
References
Assiri A, McGeer A, Perl TM, Price CS, Al Rabeeah AA, Cummings DA, Alabdullatif ZN, Assad M, Almulhim A, Makhdoom H. Hospital outbreak of Middle East respiratory syndrome coronavirus. N Engl J Med. 2013;369(5):407–16.
Bérdy J. Thoughts and facts about antibiotics: where we are now and where we are heading. J Antibiot. 2012;65(8):385–95.
Suryanarayanan T, Thirunavukkarasu N, Govindarajulu M, Sasse F, Jansen R, Murali T. Fungal endophytes and bioprospecting. Fungal Biol Rev. 2009;23(1):9–19.
Owen NL, Hundley N. Endophytes—the chemical synthesizers inside plants. Sci Prog. 2004;87(2):79–99.
Strobel G, Daisy B. Bioprospecting for microbial endophytes and their natural products. Microbiol Mol Biol Rev. 2003;67(4):491–502.
Anil P, Nikhil B, Manoj G, Prakash N. Phytochemicals and biological activities of Fagonia indica. Int Res J Pharm. 2012;3:56–9.
Waheed A, Barker J, Barton SJ, Owen CP, Ahmed S, Carew MA. A novel steroidal saponin glycoside from Fagonia indica induces cell-selective apoptosis or necrosis in cancer cells. Eur J Pharm Sci. 2012;47(2):464–73.
Singh V, Pandey R. Ethnobotany of Rajasthan. Jodhpur: Scientific Publishers; 1998.
Petrini O. Taxonomy of endophytic fungi of aerial plant tissues. Microbiology of the phyllosphere. In: Fokkema NJ, van den Heuvel J, editors; 1986.
Afzal I, Shinwari ZK, Iqrar I. Selective isolation and characterization of agriculturally beneficial endophytic bacteria from wild hemp using Canola. Pak J Bot. 2015;47(5):1999–2008.
Shweta S, Zuehlke S, Ramesha B, Priti V, Kumar PM, Ravikanth G, Spiteller M, Vasudeva R, Shaanker RU. Endophytic fungal strains of Fusarium solani, from Apodytes dimidiata E. Mey. ex Arn (Icacinaceae) produce camptothecin, 10-hydroxycamptothecin and 9-methoxycamptothecin. Phytochemistry. 2010;71(1):117–22.
Quettier-Deleu C, Gressier B, Vasseur J, Dine T, Brunet C, Luyckx M, Cazin M, Cazin J-C, Bailleul F, Trotin F. Phenolic compounds and antioxidant activities of buckwheat (Fagopyrum esculentum Moench) hulls and flour. J Ethnopharmacol. 2000;72(1):35–42.
Jagadish LK, Krishnan VV, Shenbhagaraman R, Kaviyarasan V. Comparitive study on the antioxidant, anticancer and antimicrobial property of Agaricus bisporus (JE Lange) Imbach before and after boiling. Afr J Biotechnol. 2009;8:4.
Tai Z, Cai L, Dai L, Dong L, Wang M, Yang Y, Ding Z. Antioxidant activity and chemical constituents of edible flower of Sophora viciifolia. Food Chem. 2011;126(4):1648–54.
Prieto P, Pineda M, Aguilar M. Spectrophotometric quantitation of antioxidant capacity through the formation of a phosphomolybdenum complex: specific application to the determination of vitamin E. Anal Biochem. 1999;269(2):337–41.
Jafri L, Saleem S, Ullah N, Mirza B. In vitro assessment of antioxidant potential and determination of polyphenolic compounds of Hedera nepalensis K. Koch. Arab J Chem. 2014.
Oyaizu M. Studies on products of browning reaction–antioxidative activities of products of browning reaction prepared from glucosamine. Jpn J Nutr. 1986;44:6.
Lai HY, Lim YY, Tan SP. Antioxidative, tyrosinase inhibiting and antibacterial activities of leaf extracts from medicinal ferns. Biosci Biotechnol Biochem. 2009;73(6):1362–6.
Gao J, Radwan MM, León F, Wang X, Jacob MR, Tekwani BL, Khan SI, Lupien S, Hill RA, Dugan FM. Antimicrobial and antiprotozoal activities of secondary metabolites from the fungus Eurotium repens. Med Chem Res. 2012;21(10):3080–6.
Sultanbawa Y, Cusack A, Currie M, Davis C. An innovative microplate assay to facilitate the detection of antimicrobial activity in plant extracts. J Rapid Methods Autom Microbiol. 2009;17(4):519–34.
Ma G, Khan SI, Jacob MR, Tekwani BL, Li Z, Pasco DS, Walker LA, Khan IA. Antimicrobial and antileishmanial activities of hypocrellins A and B. Antimicrob Agents Chemother. 2004;48(11):4450–2.
Yao G, Sebisubi FM, Voo LYC, Ho CC, Tan GT, Chang LC. Citrinin derivatives from the soil filamentous fungus Penicillium sp. H9318. J Braz Chem Soc. 2011;22(6):1125–9.
Franco-Correa M, Quintana A, Duque C, Suarez C, Rodríguez MX, Barea J-M. Evaluation of actinomycete strains for key traits related with plant growth promotion and mycorrhiza helping activities. Appl Soil Ecol. 2010;45(3):209–17.
Langseth L. From the editor: antioxidants and diseases of the brain. Antioxid Vitam Newslett. 1993;4:3.
Gülçin İ, Alici HA, Cesur M. Determination of in vitro antioxidant and radical scavenging activities of propofol. Chem Pharm Bull. 2005;53(3):281–5.
Maisuthisakul P, Suttajit M, Pongsawatmanit R. Assessment of phenolic content and free radical-scavenging capacity of some Thai indigenous plants. Food Chem. 2007;100(4):1409–18.
Nongkhlaw FM, Joshi SR. Investigation on the bioactivity of culturable endophytic and epiphytic bacteria associated with ethnomedicinal plants. J Infect Dev Ctries. 2015;9(09):954–61.
Abdel-Hameed ESS. Total phenolic contents and free radical scavenging activity of certain Egyptian Ficus species leaf samples. Food Chem. 2009;114(4):1271–7.
Singh N, Rajini P. Free radical scavenging activity of an aqueous extract of potato peel. Food Chem. 2004;85(4):611–6.
Rafat A, Philip K, Muniandy S. A novel source of bioactive compounds: endophytic bacteria isolated from Centella asiatica. J Pure Appl Microbiol. 2012;6(1):1.
Swarnalatha Y, Saha B, Choudary L. Bioactive compound analysis and antioxidant activity of endophytic bacterial extract from Adhathoda beddomei. Asian J Pharm Clin Res. 2015;8:70–2.
Kostova I, Bhatia S, Grigorov P, Balkansky S, Parmar SV, Prasad KA, Saso L. Coumarins as antioxidants. Curr Med Chem. 2011;18(25):3929–51.
Jalgaonwala RE, Mahajan RT. Isolation and characterization of endophytic bacterial flora from some Indian medicinal plants. Asian J Res Chem. 2011;4(2):56.
Sun H, He Y, Xiao Q, Ye R, Tian Y. Isolation, characterization, and antimicrobial activity of endophytic bacteria from Polygonum cuspidatum. Afr J Microbiol Res. 2013;7(16):1496–504.
Ashford R. The leishmaniases as model zoonoses. Ann Trop Med Parasitol. 1997;91(7):693–702.
Kassi M, Kasi PM, Marri SM, Tareen I, Khawar T. Vector control in cutaneous leishmaniasis of the old world: a review of literature. Dermatol Online J. 2008;14(6):1.
Fatima H, Khan K, Zia M, Ur-Rehman T, Mirza B, Haq IU. Extraction optimization of medicinally important metabolites from Datura innoxia Mill: an in vitro biological and phytochemical investigation. BMC Complement Altern Med. 2015;15(1):376.
Barbara W, Saxena G, Wanggui Y, Kau D, Wrigley S, Stokes R. Identifying protein kinase inhibitors using an assay based on inhibition of aerial hyphae formation in streptomyces. J Antibiot. 2002;55(4):407–16.
Kluge B, Vater J, Salnikow J, Eckart K. Studies on the biosynthesis of surfactin, a lipopeptide antibiotic from Bacillus subtilis ATCC 21332. FEBS Lett. 1988;231(1):107–10.
Authors’ contributions
LR participated in the overall experimental design and wrote the manuscript. ZKS participated in providing lab facilities and management of the study. II and FT participated in the coordination of the study and analyzing the data sequencing. LR participated in graphical and statistical data analysis. All authors read and approved the final manuscript.
Acknowledgements
We acknowledge Ikram Ullah (Ph.D. scholar), Ali Talha Khalil (Ph.D. scholar) and Tariq Khan (Ph.D. scholar) from Department of Biotechnology, Quaid-i-Azam University Islamabad for their help and valuable advices during research work. We acknowledge Molecular Systematics and Applied Ethnobotany Lab, Department of Biotechnology, Quaid-i-Azam Univeristy Islamabad for providing the platform to perform the experiments.
Competing interests
The authors declare that they have no competing interests.
Availability of data and materials
The nucleotide Genome sequences of endophytic bacteria obtained in this work were deposited in GenBank under Accession Numbers KT367786–KT367793.
Consent for publication
It is not applicable because the manuscript does not contain anyone’s individual data.
Ethics approval and consent to participate
This research was approved by the Research Ethics Committee of Quaid-i-Azam Univeristy Islamabad Pakistan.
Funding
The work was not funded from any source and further that the institution is not providing any funds for its publication.
Publisher’s Note
Springer Nature remains neutral with regard to jurisdictional claims in published maps and institutional affiliations.
Author information
Authors and Affiliations
Corresponding author
Rights and permissions
Open Access This article is distributed under the terms of the Creative Commons Attribution 4.0 International License (http://creativecommons.org/licenses/by/4.0/), which permits unrestricted use, distribution, and reproduction in any medium, provided you give appropriate credit to the original author(s) and the source, provide a link to the Creative Commons license, and indicate if changes were made. The Creative Commons Public Domain Dedication waiver (http://creativecommons.org/publicdomain/zero/1.0/) applies to the data made available in this article, unless otherwise stated.
About this article
Cite this article
Rahman, L., Shinwari, Z.K., Iqrar, I. et al. An assessment on the role of endophytic microbes in the therapeutic potential of Fagonia indica . Ann Clin Microbiol Antimicrob 16, 53 (2017). https://doi.org/10.1186/s12941-017-0228-7
Received:
Accepted:
Published:
DOI: https://doi.org/10.1186/s12941-017-0228-7